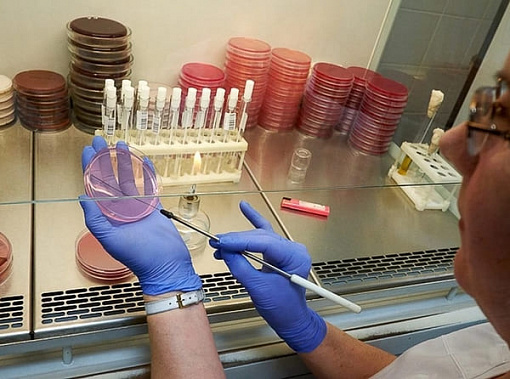
На Дону зарегистрировано еще 94 случая коронавируса

Дата публикации:
8 июл 2020 г.
По статистике Роспотребнадзора, в Ростовской области на 8 июля выявлено 10 350 случаев COVID-19. За сутки выздоровели 315 человек. Подтверждена гибель от COVID-19 еще троих жителей Дона.
1408
Вчера донские лаборатории провели 3 791 тестирований на коронавирус — обнаружили еще 94 инфицированных человек.
- Из их числа 48 жителей Ростова-на-Дону.
- В Волгодонске и Красносулинском районе зарегистрировано еще по 6 случаев.
- В Миллеровском районе — 5 новых случаев.
- В Шахтах, Батайске и Мясниковском районе — по 3 случая инфицирования.
- В Кагальницком, Морозовском, Зерноградском и Тарасовском районах — по 2 случая заражения.
- Единичные новые случаи выявлены в Таганроге и Гукове, Звереве, Волгодонском, Мартыновском, Кашарском, Чертковском Дубовском, Неклиновском, Константиновском, Орловском, и Аксайском районах Дона.
Четверть выявленных заражений приходится на молодых жителей Дона, почти половина — на дончан от 46 до 65 лет. Доля детей составляет 2,1%, пожилых людей от 80 лет — 5,3.
В данный момент лечение от COVID-19 проходят 2 818 жителей Ростовской области, из них в стационарных условиях — 635 человек. На аппаратах искусственной вентиляции легких — 33 пациента.
Рекордное со 2 июля число пациентов вчера были признаны выздоровевшими — 315 жителей Ростовской области. Всего на Дону переболели COVID-19 7 383 человека.
Подтверждена гибель от COVID-19 еще троих донских жителей. Не смогли перебороть коронавирус нового типа 41-летний мужчина с рядом хронических болезней, который слишком поздно обратился к врачам, а также 60-летняя жительница с хроническими сердечно-сосудистыми заболеваниями и 74-летний мужчина, страдавший от болезней сердца и нервной системы. Количество погибших от коронавируса в регионе выросло до 149 человек.
В России на данный момент 700 792 случаев инфицирования коронавирусом, из них выздоровели 472 511 наших соотечественников. Суточный прирост составил 6 562 новых случаев коронавирусной инфекции, выписаны за вчерашний день 8 631 жителей России.